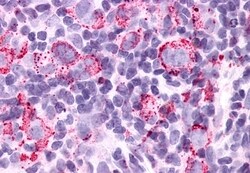
Invitrogen GPR34 Polyclonal Antibody 50 &mu;g; Unconjugated:Antibodies,

missing translation for 'onlineSavingsMsg'
Learn More
Learn More
Invitrogen™ GPR34 Polyclonal Antibody


Rabbit Polyclonal Antibody
Supplier: Invitrogen™ PA533697
Description
Percent identity with other species by BLAST analysis: Human, Chimpanzee, Gorilla, Gibbon, Monkey, Bovine, Horse (100%) Marmoset, Mouse, Rat, Elephant, Guinea pig (94%).
G protein-coupled receptors (GPCRs), such as GPR34, are integral membrane proteins containing 7 putative transmembrane domains (TMs). These proteins mediate signals to the interior of the cell via activation of heterotrimeric G proteins that in turn activate various effector proteins, ultimately resulting in a physiologic response.Identifiants chimiques
| GPR34 | |
| Store at 4°C short term. For long term storage, store at -20°C, avoiding freeze/thaw cycles. | |
| Polyclonal | |
| Liquid | |
| IgG | |
| Human, Bovine, Horse | |
| Gpr34 | |
| G protein-coupled receptor 34; Gpr34; G-protein-coupled receptor; G-protein-coupled receptor GPR34; Lypsr1; probable G-protein coupled receptor 34 | |
| Gpr34 | |
| Primary | |
| Antigen affinity chromatography |
| 1 mg/mL | |
| Immunohistochemistry (Paraffin) | |
| Unconjugated | |
| Rabbit | |
| RUO | |
| PBS with 0.1% sodium azide | |
| Q9UPC5 | |
| 100050641, 100139092, 2857 | |
| Synthetic 17 amino acid peptide from 2nd cytoplasmic domain of human GPR34. | |
| Antibody |
Spécifications
| GPR34 | |
| Polyclonal | |
| Unconjugated | |
| Gpr34 | |
| G protein-coupled receptor 34; Gpr34; G-protein-coupled receptor; G-protein-coupled receptor GPR34; Lypsr1; probable G-protein coupled receptor 34 | |
| Rabbit | |
| Antigen affinity chromatography | |
| RUO | |
| 100050641, 100139092, 2857 | |
| Store at 4°C short term. For long term storage, store at -20°C, avoiding freeze/thaw cycles. | |
| Liquid |
| Immunohistochemistry (Paraffin) | |
| 1 mg/mL | |
| PBS with 0.1% sodium azide | |
| Q9UPC5 | |
| Gpr34 | |
| Synthetic 17 amino acid peptide from 2nd cytoplasmic domain of human GPR34. | |
| 50 μg | |
| Primary | |
| Human, Bovine, Horse | |
| Antibody | |
| IgG |